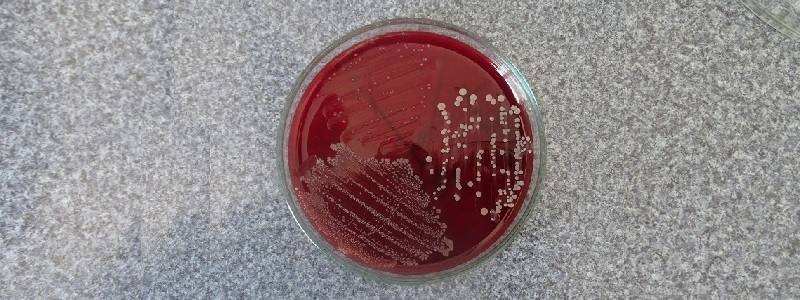
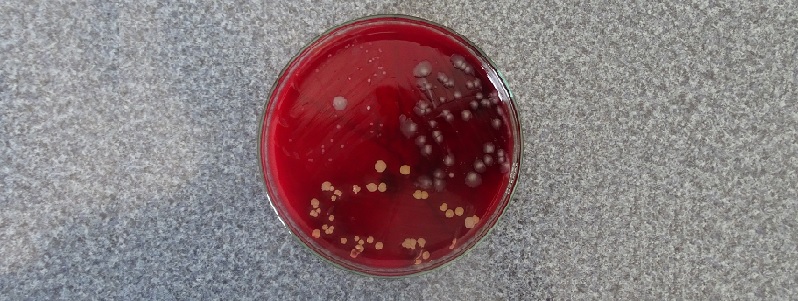
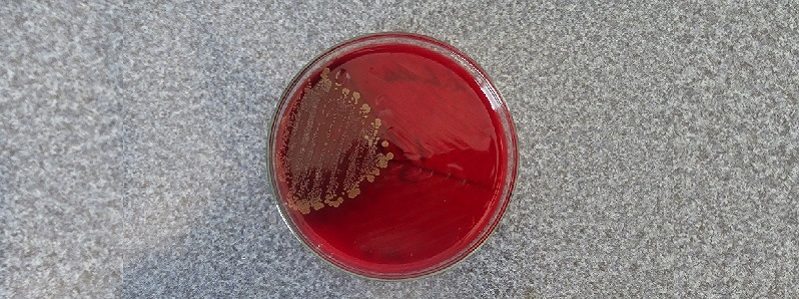
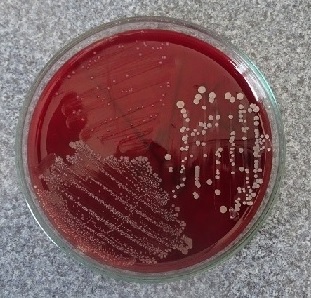

| |
LABSURLaboratorio Veterinario |
|---|

BACTERIOLOGIA
Exámen:
Cultivos Sta.aureus
Cultivos leche
Cultivo de Calostro
Cultivo Secreciones
Cultivo más antibiograma (lactancia o secado)
Cultivo más antibiograma lactancia y secado
Cultivo de Estanque (BTA)
UFC
Cultivo de Agua
Análisis Recuento Células Somáticas
Grasa Proteína Urea